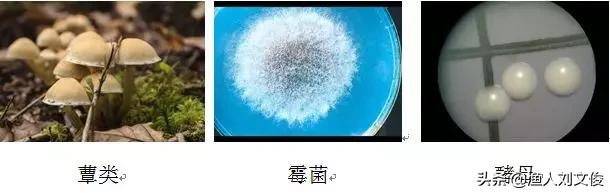
真菌的分类初识：真菌与细菌不同，是一种真核生物

专注水产适用技术,奉献实用养鱼信息!

最近在做海洋微生物普查的微生物分离工作,发现对真菌的认识严重不足,特别是对其形态和分类的认识过于片面了,因此,在查阅相关资料后,笔者对真菌的分类及形态学做一定的初步梳理,以便为以后的工作打下基础。
说到真菌,一般人第一反应是蘑菇或者是霉菌,很少有人会第一时间意识到像酵母和念球菌等等也是真菌,笔者以前就犯了这样的错误,因此对酵母型真菌的认识很少。
我们都知道,真菌与细菌不同,是一种真核生物。最常见的真菌是各类蕈类,另外真菌也包括霉菌和酵母,分别对应三种真菌形态类型,即蕈状、丝状(霉菌型)和酵母型。真菌区别于其他物种,如植物、动物和细菌的关键在于,真菌细胞的细胞壁主要成分为壳多糖。
真菌界(Eumycetes)分为四门,分别为壶菌门(Chytridiomycota)、接合菌门(Zygomycota)、子囊菌门(Ascomycota)、担子菌门(Basidiomycota)。
根据性器官的形态及交配方式,一些科学家认为真菌来自藻类。他们认为壶菌门自原藻演化而来,其中的水霉目演自无隔藻。水生壶菌门真菌是原始型,通过由水生到陆生的演化过程,逐渐形成接合菌门、子囊菌门和担子菌门。

壶菌门的游动细胞具有“9+2”结构的鞭毛,能在水中游动,游动孢子具有一根后生尾鞭式鞭毛。水生动物常患的水霉病即由此菌门引起。

接合菌门由低等的带鞭毛的水生真菌发展为不游动的陆生种类。各种丝状型真菌即属于此门。

丝状型真菌体呈丝状,丛生,可产生多种形式的孢子。多腐生。种类很多,常见的有根霉、毛霉、曲霉和青霉等。
子囊菌门是真菌中最大的类群,它与担子菌门被称为高等真菌。其区别于其他真菌的一个特征是产生子囊。如地衣、冬虫夏草、羊肚菌、酵母等。

酵母菌的菌落与细菌有些相似,但较细菌菌落大而厚,一般呈油脂或蜡脂状,表面光滑、湿润、呈乳白色或红色。有些种的菌落可因培养时间过长而表面皱缩。
担子菌门为高等真菌,即我们常食用的各种蕈类。
(作者:樊慧敏)

水产实践人士,共谋渔业繁荣!更多精彩内容敬请关注头条号@渔人刘文俊,或请登录:西南渔业网。本文如需转载请注明出处,如有不同见解或者内容补充请留言或评论分享!